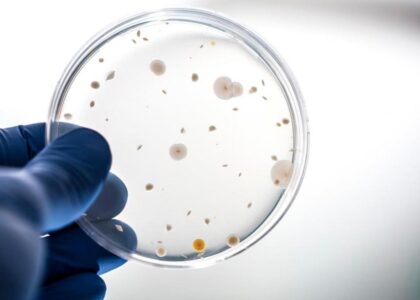
Clostridium Diagnostics Industry

Clostridium Diagnostics Market Set to Experience Rapid Growth USD 7.8 Billion by 2032 at a 12.2% of CAGR, Driven by Rising Disease Prevalence and Awareness Campaigns
The global clostridium diagnostics market is projected to grow significantly, rising from US$ 2.5 billion